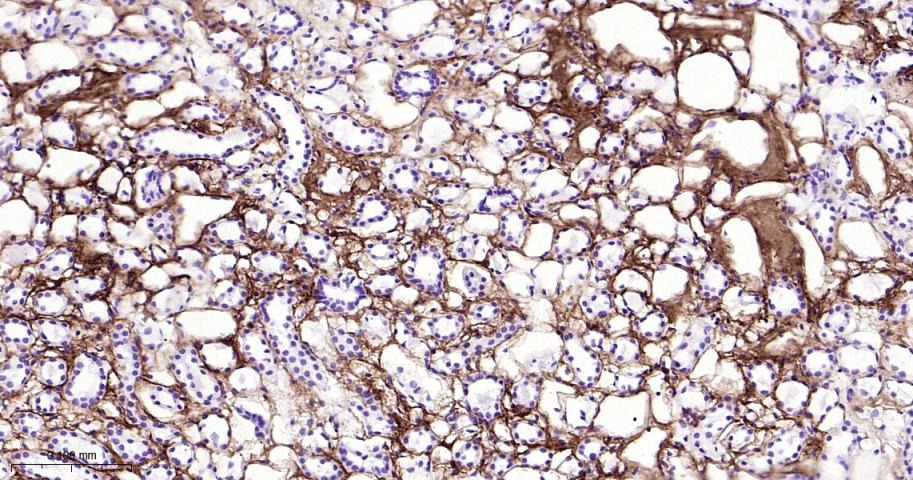
verifiedActivity

您的购物车当前为空
您的购物车当前为空
Anti-Collagen I/COL1A1 Polyclonal Antibody 2
Synonyms: Type I procollagen, Pro alpha 1(I) collagen, Osteogenesis Imperfecta Type IV, OI4, Collagen type I alpha 2, Collagen type I alpha 1, Collagen type I, Collagen Type 1, Collagen Of Skin Tendon And Bone, Collagen I alpha 2 polypeptide, Collagen I alpha 1 polypeptide, COL1A2, COL1A1, CO1A1, alpha 2 type I collagen, alpha 1 type I collagen货号 TMAB-00455 一键复制产品信息
Anti-Collagen I/COL1A1 Polyclonal Antibody 2 是一种 Rabbit 抗体,靶向 Histamine。Anti-Collagen I/COL1A1 Polyclonal Antibody 2 可用于 FCM,ICC/IF,IF,IHC-Fr,IHC-P,WB。
Anti-Collagen I/COL1A1 Polyclonal Antibody 2
一键复制产品信息货号 TMAB-00455
别名 Type I procollagen, Pro alpha 1(I) collagen, Osteogenesis Imperfecta Type IV, OI4, Collagen type I alpha 2, Collagen type I alpha 1, Collagen type I, Collagen Type 1, Collagen Of Skin Tendon And Bone, Collagen I alpha 2 polypeptide, Collagen I alpha 1 polypeptide, COL1A2, COL1A1, CO1A1, alpha 2 type I collagen, alpha 1 type I collagen
Anti-Collagen I/COL1A1 Polyclonal Antibody 2 是一种 Rabbit 抗体,靶向 Histamine。Anti-Collagen I/COL1A1 Polyclonal Antibody 2 可用于 FCM,ICC/IF,IF,IHC-Fr,IHC-P,WB。
Anti-Collagen I/COL1A1 Polyclonal Antibody 2
| 规格 | 价格 | 库存 | 数量 |
|---|---|---|---|
| 50 μL | ¥ 1,165 | 5日内发货 | |
| 100 μL | ¥ 1,975 | 5日内发货 | |
| 200 μL | ¥ 2,790 | 5日内发货 |
库存状态实时更新,以官网显示为准,现货产品可直接加购物车下单
大包装 & 定制
加入购物车
TargetMol的所有产品仅用作科学研究或药证申报,不能被用于人体,我们不向个人提供产品和服务。请您遵守承诺用途,不得违反法律法规规定用于任何其他用途。
产品介绍
生物活性
抗原信息
化学信息
储存&溶解度
| 产品描述 | Anti-Collagen I/COL1A1 Polyclonal Antibody 2 is a Rabbit antibody targeting Histamine. Anti-Collagen I/COL1A1 Polyclonal Antibody 2 can be used in FCM,ICC/IF,IF,IHC-Fr,IHC-P,WB. |
| 别名 | Type I procollagen, Pro alpha 1(I) collagen, Osteogenesis Imperfecta Type IV, OI4, Collagen type I alpha 2, Collagen type I alpha 1, Collagen type I, Collagen Type 1, Collagen Of Skin Tendon And Bone, Collagen I alpha 2 polypeptide, Collagen I alpha 1 polypeptide, COL1A2, COL1A1, CO1A1, alpha 2 type I collagen, alpha 1 type I collagen |
| Ig Type | IgG |
| 反应种属 | Human,Mouse,Rat |
| 验证活性 | 1. 25 μg total protein per Lane of various lysates probed with Collagen I polyclonal antibody, unconjugated (TMAB-00455) at 1:1000 dilution and 4°C overnight incubation. Followed by conjugated secondary antibody incubation at RT for 60 min. 2. U-118 MG (H) cells were treated with or without BFA, 25 μg total protein per Lane of cell lysates probed with Collagen I polyclonal antibody, unconjugated (TMAB-00455) at 1:1000 dilution and 4°C overnight incubation. Followed by conjugated secondary antibody incubation at RT for 60 min. 3. Paraformaldehyde-fixed, paraffin embedded Mouse Lung; Antigen retrieval by boiling in sodium citrate buffer (pH6.0) for 15 min; The section was incubated with Collagen I Polyclonal Antibody, Unconjugated (TMAB-00455) at 1:800 overnight at 4°C, followed by conjugation to the secondary antibody and DAB staining. 4. Paraformaldehyde-fixed, paraffin embedded Rat Lung; Antigen retrieval by boiling in sodium citrate buffer (pH6.0) for 15 min; The section was incubated with Collagen I Polyclonal Antibody, Unconjugated (TMAB-00455) at 1:800 overnight at 4°C, followed by conjugation to the secondary antibody and DAB staining. 5. Paraformaldehyde-fixed, paraffin embedded Human Lung; Antigen retrieval by boiling in sodium citrate buffer (pH6.0) for 15 min; The section was incubated with Collagen I Polyclonal Antibody, Unconjugated (TMAB-00455) at 1:800 overnight at 4°C, followed by conjugation to the secondary antibody and DAB staining. 6. Paraformaldehyde-fixed, paraffin embedded Mouse Liver; Antigen retrieval by boiling in sodium citrate buffer (pH6.0) for 15 min; The section was incubated with Collagen I Polyclonal Antibody, Unconjugated (TMAB-00455) at 1:800 overnight at 4°C, followed by conjugation to the secondary antibody and DAB staining. 7. Paraformaldehyde-fixed, paraffin embedded Human Liver; Antigen retrieval by boiling in sodium citrate buffer (pH6.0) for 15 min; The section was incubated with Collagen I Polyclonal Antibody, Unconjugated (TMAB-00455) at 1:800 overnight at 4°C, followed by conjugation to the secondary antibody and DAB staining. 8. Paraformaldehyde-fixed, paraffin embedded Mouse Skin; Antigen retrieval by boiling in sodium citrate buffer (pH6.0) for 15 min; The section was incubated with Collagen I Polyclonal Antibody, Unconjugated (TMAB-00455) at 1:800 overnight at 4°C, followed by conjugation to the secondary antibody and DAB staining. 9. Paraformaldehyde-fixed, paraffin embedded Rat Skin; Antigen retrieval by boiling in sodium citrate buffer (pH6.0) for 15 min; The section was incubated with Collagen I Polyclonal Antibody, Unconjugated (TMAB-00455) at 1:800 overnight at 4°C, followed by conjugation to the secondary antibody and DAB staining. 10. Paraformaldehyde-fixed, paraffin embedded Rat Colon; Antigen retrieval by boiling in sodium citrate buffer (pH6.0) for 15 min; The section was incubated with Collagen I Polyclonal Antibody, Unconjugated (TMAB-00455) at 1:800 overnight at 4°C, followed by conjugation to the secondary antibody and DAB staining. 11. Paraformaldehyde-fixed, paraffin embedded Human Colon Cancer; Antigen retrieval by boiling in sodium citrate buffer (pH6.0) for 15 min; The section was incubated with Collagen I Polyclonal Antibody, Unconjugated (TMAB-00455) at 1:800 overnight at 4°C, followed by conjugation to the secondary antibody and DAB staining. 12. Paraformaldehyde-fixed, paraffin embedded Human Prostate Cancer; Antigen retrieval by boiling in sodium citrate buffer (pH6.0) for 15 min; The section was incubated with Collagen I Polyclonal Antibody, Unconjugated (TMAB-00455) at 1:800 overnight at 4°C, followed by conjugation to the secondary antibody and DAB staining. 13. Paraformaldehyde-fixed, paraffin embedded Human Prostate; Antigen retrieval by boiling in sodium citrate buffer (pH6.0) for 15 min; The section was incubated with Collagen I Polyclonal Antibody, Unconjugated (TMAB-00455) at 1:800 overnight at 4°C, followed by conjugation to the secondary antibody and DAB staining. 14. Paraformaldehyde-fixed, paraffin embedded Human Breast Cancer; Antigen retrieval by boiling in sodium citrate buffer (pH6.0) for 15 min; The section was incubated with Collagen I Polyclonal Antibody, Unconjugated (TMAB-00455) at 1:800 overnight at 4°C, followed by conjugation to the secondary antibody and DAB staining. 15. Paraformaldehyde-fixed, paraffin embedded Human Esophagus Cancer; Antigen retrieval by boiling in sodium citrate buffer (pH6.0) for 15 min; The section was incubated with Collagen I Polyclonal Antibody, Unconjugated (TMAB-00455) at 1:800 overnight at 4°C, followed by conjugation to the secondary antibody and DAB staining. 16. Paraformaldehyde-fixed, paraffin embedded Human Endometrial Cancer; Antigen retrieval by boiling in sodium citrate buffer (pH6.0) for 15 min; The section was incubated with Collagen I Polyclonal Antibody, Unconjugated (TMAB-00455) at 1:800 overnight at 4°C, followed by conjugation to the secondary antibody and DAB staining. 17. Paraformaldehyde-fixed, paraffin embedded Human Kidney; Antigen retrieval by boiling in sodium citrate buffer (pH6.0) for 15 min; The section was incubated with Collagen I Polyclonal Antibody, Unconjugated (TMAB-00455) at 1:800 overnight at 4°C, followed by conjugation to the secondary antibody and DAB staining. 18. Paraformaldehyde-fixed, paraffin embedded Human Placenta; Antigen retrieval by boiling in sodium citrate buffer (pH6.0) for 15 min; The section was incubated with Collagen I Polyclonal Antibody, Unconjugated (TMAB-00455) at 1:800 overnight at 4°C, followed by conjugation to the secondary antibody and DAB staining. 19. Paraformaldehyde-fixed, paraffin embedded Human Uterus; Antigen retrieval by boiling in sodium citrate buffer (pH6.0) for 15 min; The section was incubated with Collagen I Polyclonal Antibody, Unconjugated (TMAB-00455) at 1:800 overnight at 4°C, followed by conjugation to the secondary antibody and DAB staining. 20. 4% Paraformaldehyde-fixed U-87MG (H) cell; Triton X-100 at RT for 20 min; Antibody incubation with (Collagen I) polyclonal Antibody, unconjugated (TMAB-00455) 1:100, 90 min at 37°C; followed by conjugated Goat Anti-Rabbit IgG antibody (green) at 37°C for 90 min, DAPI (blue) was used to stain the cell nucleus. PBS instead of the primary antibody was used as the blank control. 21. The U-87MG (H) cells were fixed with 4% PFA (10 min at room temperature) and then permeabilized with 90% ice-cold methanol for 20 min at-20°C,the cells then were incubated in 5% BSA to block non-specific protein-protein interactions (30 min at room temperature). Primary Antibody (green): Rabbit Anti-Collagen I antibody (TMAB-00455,1:100); Secondary Antibody (white blue): Goat anti-Rabbit IgG-BF488: 1 μg/test.Blank control (black): PBS. 22. The U2-OS (H) cells were fixed with 4% PFA (10 min at room temperature) and then permeabilized with 90% ice-cold methanol for 20 min at-20°C,the cells then were incubated in 5% BSA to block non-specific protein-protein interactions (30 min at room temperature). Primary Antibody (green): Rabbit Anti-Collagen I antibody (TMAB-00455,1:100); Secondary Antibody (white blue): Goat anti-Rabbit IgG-BF488: 1 μg/test. Blank control (black): PBS. 23. 4% Paraformaldehyde-fixed U2-OS (H) cell; Triton X-100 at RT for 20 min; Antibody incubation with (Collagen I) polyclonal Antibody, unconjugated (TMAB-00455) 1:100, 90 min at 37°C; followed by conjugated Goat Anti-Rabbit IgG antibody (green) at 37°C for 90 min, DAPI (blue) was used to stain the cell nucleus. PBS instead of the primary antibody was used as the blank control. |
| 应用 | FCMICC/IFIFIHC-FrIHC-PWB |
| 推荐剂量 | FCM=1:50-100; ICC/IF=1:100-500; IF=1:500-1000; IHC-Fr=1:500-1000; IHC-P=1:500-1000; WB=1:500-2000 |
| 抗体种类 | Polyclonal |
| 宿主来源 | Rabbit |
| 亚细胞定位 | Secreted, extracellular space, extracellular matrix. |
| 组织特异性 | Forms the fibrils of tendon, ligaments and bones. In bones the fibrils are mineralized with calcium hydroxyapatite. |
| 构建方式 | Polyclonal Antibody |
| 纯化方式 | Protein A purified |
| 性状 | Liquid |
| 缓冲液 | 0.01M TBS (pH7.4) with 1% BSA, 0.02% Proclin300 and 50% Glycerol. |
| 浓度 | 1 mg/mL |
| 研究背景 | Collagens are highly conserved throughout evolution and are characterised by an uninterrupted "Glycine X Y" triplet repeat that is a necessary part of the triple helical structure. Type I collagen (95 kDa) is found in bone, cornea, skin and tendon. Mutations in the encoding gene are associated with osteogenesis imperfecta, Ehlers Danlos syndrome, and idiopathic osteoporosis. Reciprocal translocations between chromosomes 17 and 22, where this gene and the gene for Platelet-derived growth factor beta are located, are associated with a particular type of skin tumor called dermatofibrosarcoma protuberans, resulting from unregulated expression of the growth factor. |
| 免疫原 | KLH conjugated synthetic peptide: human Collagen I |
| 抗原种属 | Human |
| 基因名称 | COL1A1 |
| 基因ID | |
| 蛋白名称 | Collagen alpha-1(I) chain |
| Uniprot ID | |
| 研究领域 | Collagen,Osteogenesis |
| 功能 | Type I collagen is a member of group I collagen (fibrillar forming collagen). |
| 分子量 | Theoretical: 130 kDa. Actual: 130-200 kDa. |
| 储存方式 | Store at -20°C or -80°C for 12 months. Avoid repeated freeze-thaw cycles. |
| 运输方式 | Shipping with blue ice. |
计算器
Related Tags: buy Anti-Collagen I/COL1A1 Polyclonal Antibody 2 | purchase Anti-Collagen I/COL1A1 Polyclonal Antibody 2 | Anti-Collagen I/COL1A1 Polyclonal Antibody 2 cost | order Anti-Collagen I/COL1A1 Polyclonal Antibody 2 | Anti-Collagen I/COL1A1 Polyclonal Antibody 2 molecular weight



 还可以
还可以

 |
|